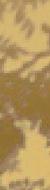

Climb aboard the historic Cumbres & Toltec Scenic Railroad which operates in the scenic landscapes of southern Colorado and northern New Mexico. Journey back in time experiencing the Old West as it was in 1880, as you venture over the highest mountain pass reached by rail, cross gorges and trestles, blast through tunnels, and chug across alpine meadows and high deserts. Depart from Antonito, Colorado or Chama, New Mexico for a ride of a lifetime!












































































































































































Fall is a time many of our resort communities slow down — the “shoulder season” brings fewer tourists as little ones are back in their classrooms — but that doesn’t mean visitors and locals can’t find fun, exciting activities. Here is a small sample:

11 & 12









OCT 11–13
Brandenburg Park The 19th Annual Red River Oktoberfest celebrates autumn in New Mexico with craft beer, wines and spirits, authentic German food, local vendors, live music, contests and games, kid’s activities and more. Children under 12 enter free, and pets on leashes are welcome. Bring ID — they check at the gate. redriverchamber.org/oktoberfest
OCT 25-27
Celebrating 41 years, the Taos Mountain Balloon Rally is truly a Taos County event with morning mass ascensions, a trick or treat balloon glow, free tethered balloon rides, ballooning educations and demonstrations, live music, arts, crafts and food vendors. All events are free and weather dependent. taosballoonrally.com


$35 registration fee
September 27 – October 6, 2024
San Francisco de Asís School House & Auditorium
36 Espinoza Rd, Ranchos de Taos, NM














































































































































































Fall Show - Sept. 7 - 23




Wilder Nightingale Fine Art
119 Kit Carson Road

















The Taos Artist Organization’s 17th Taos Studio Tour brings together more than 20 local artists who open their studios to the public for a self-guided tour over Labor Day weekend. Works include paintings, pottery, quilts, jewelry, fine art photography and sculpture. Look for a Preview Show Party,



































































St Francis de Assisi Schoolhouse and Auditorium 36 Espinoza Rd, Ranchos de Taos / taosfallarts.com
Taos Fall Arts Festival celebrates 50 years this year and Lisa Harris, Taos Fall Arts Festival Board President, says the Board is very excited to share this year’s event at the muchloved former Saint Francis de Assisi Schoolhouse and Auditorium in Ranchos de Taos.
“The Fall Arts is a celebration and coming together of the rich history, diverse cultures, artistic talent and traditions that make Taos so special and unique. The focus this year will be celebrating Taos’ rich history and traditions interwoven with modern art and culture. One very special person who started the festival, Barbara Brenner who resides in town, will be honored this year. We will be renaming the Lifetime Achievement Award in her name.”
According to the book Remarkable Women of Taos, “Barbara Brandenburg Brenner, granddaughter of Oscar E. Berninghaus, was born and raised in Taos at a time when all the ‘founding’ artists were still alive and working in Taos. She had the good fortune to know all of them, although for some she just has childhood memories.…”
Brenner’s family history inspired her to work with art and cultural organizations in Taos, including as a founding member of the Taos Art Festival, which began in 1974. The original organizers staged Taos Arts at the homes of art patrons who wanted to support and promote local artists. Over the years the festival has grown in popularity, and the venues have changed, but, according to the
group’s website, “the mission has remained constant: to celebrate the visual arts and artists of Taos County; to encourage the growth of emerging artists; and to continue hosting an event where artists could come together, exhibit, and market their work for the delight and appreciation of the community.”
The special 50th anniversary celebration has inspired new awards as well, Harris says. “We are inviting artists to think outside the box, working outside of their comfort zone, and submit a piece that is completely different for them, whether it be a new medium or new subject. From this we will be selecting an award winner for the new Maverick Award, in memory and celebration of Abe Paul.”
The Taos Fall Arts Festival is a notfor-profit volunteer organization dedicated to promoting Taos County Artists and honoring and showcasing the variety of art forms and diversity of cultures, ages and traditions in Taos. Donations of all forms are graciously accepted. To make a taxdeductible donation or to become a TFAF sponsor, contact Lisa Harris, TFAF Board President and Executive Director at taosfallartsfestival@gmail.com
This year’s TFAF curator is local gallery owner and artist Rob Nightingale of Wilder Nightingale Fine Art. Exhibition layout designer is artist and award winning space designer, Ricky Pass (former TFAF VP). Judges will be a panel of museum and gallery directors and curators.
Taos Fall Arts Festival Awards
2024 Poster Artist Winner —
Monique Belitz, a national and international exhibiting landscape artist. “My work is about the joy of living in a Permaculture community, ruled by the powerful forces of the mountains and weather.”
Poster Artist Award: $500
Maverick Award: $500
Best in Show, 2D Art: $500
Best in Show, 3D Art: $500
Best in Show, Decorative Art: $500
Honorable Mention(s): No prize
People’s Choice: No prize
2024 Abe Paul - Maverick Award
This is a new award that honors and celebrates the life of Abe Paul inviting artists to think outside the box and reach outside their comfort level to create something new and exciting.
The winning artist will have an opportunity to exhibit their work at a downtown gallery. Judges to be Georgia Gersh, Rob Nightingale and Greg Moon. The award is sponsored by Chef Robin Valdez of La Luna restaurant at La Fonda Hotel.
2024 Heritage Trust Poster Artist Award
The Taos Fall Arts Festival is grateful for the generosity of Heritage Trust Company of New Mexico, who hold the complete collection of the Taos Fall Arts Festival posters, since the first year of the festival. Their sponsorship covers the cash award, production of the posters and will host an event that will celebrate 30 years of Heritage Trust and 50 years of Taos Fall Arts.
2024 Couse-Sharp Heritage Awards Award winners will be chosen during the Taos Fall Arts Festival. Artists must be of Hispano or Indigenous descent and are encouraged to participate. Four $500 awards ($2,500 in total) will be given in the following categories: Hispano Traditional, Hispano Contemporary, Indigenous Traditional, Indigenous Contemporary. Sponsored by Couse Sharp Historic Site.
2024 Barbara Brenner Lifetime Achievement Award Winners
The Barela Family and extended family members: Carlos, Daniel, Luis, Daniel Jr., and Roberto Barela, plus Daniel Rael and Patricia Barela Rael. Art created by the great Taos santero Patrociño Barela (1900-1964) seemed to flow out of the wood. His gorgeous, recognizable style — and the santero tradition — is evident in works created to this day by his grandchildren and great-grandchildren.
Inspired by an exhibition of his grandfather’s work, Luis Barela Jr. taught himself to carve at age 19 by studying photos of Patrociño’s carvings. In 1988, Carlos Barela’s employer learned about his heritage and insisted that he was meant to carve, even helping him acquire his first piece of wood.
Daniel Barela is the only one of Luis Jr.’s children to pursue a carving career. “Now that I’m older, I appreciate more about keeping the tradition going — my great-grandfather’s tradition, but also the traditions of the Spanish colonial, making santos and kind of spreading the word of the Catholic religion,” Daniel said.
Carlos’ son Roberto Barela carved his first bulto at 11, learning the basics from his father and uncle. “I feel I’m still growing as an artist. I’m still changing certain things in my style, still calibrating myself. And I always see it as a challenge to do better work all the time.”
Daniel Rael began carving around 1980 and learned by watching his brotherin-law Carlos Barela and wood-carver Ernesto Salazar.
Patricia Barela Rael began carving about 15 years ago. She has noted, “I am proud that we were inspired to carry on the tradition.”
A donation to the Martinez Havienda will be made this year in honor of the Barela Family. Check and Award will be presented during the awards ceremony on Opening Night. For the Complete Event Schedule please refer to taosfallarts.com or the Taos Fall Arts Festival Facebook Page


Lisa Harris, Vicki Squires, Alexander Paul, Elizabeth Simmons, Tina Jo Martinez, Angelina Burns, Lily Woodbury
Special Thanks
FRIDAY, SEPT 27
Festival and Gallery Opening Night
St Francis de Assisi
Schoolhouse and Auditorium, 4–7 p.m.
SEPT 28–OCT 6
Gallery hours
St Francis de Assisi
Schoolhouse and Auditorium, 10 a.m.-5 p.m.
NM Arts, Coca-Cola, Waste Management, Taos News, Wolfgang SpaWorks, Cids, BMW, Fred Winters, Sasha Vom Dorp, Ruthann McCarthy
Volunteer TFAF angels: Kevin Anderson, Renate Hume, Deborah Batson, Jeanine Borree, Jeannie Clawson, Max Caldwell, Ron Gersten, Danielle Kennedy and other participating artists and friends
Taos Fall Arts debuts in an inspired new venue
For the first time Taos Fall Arts events will take place in the historic St Francis de Assisi School House and Campus. In the early 1900s, the land was donated by Jesus and Feloniz Martinez for a Catholic school.
The school, which operated from 1935 to 1968 and from 1979 to 2006, fostered the education of many children who grew up in Ranchos de Taos.
“This is a location that is steeped deeply in meaning, memories and significance for generations of Taoseños,” Harris says. “Ranchos de Taos is deeply rooted in tradition. The community has stories, photographs, history and a deep sense of commitment to keep tradition alive and look out for one another. Hosting the Taos Fall Arts at the St Francis de Assisi School House and Campus will be a step back in time for many and an opportunity for the public to get to see the architectural craftsmanship and love that went into building these structures. There will also be a docent-led tour of the old convent and time for Q&A.”
Harris adds, “The current owners of St Francis de Assisi School House and Campus will be giving use of the space at no cost as a gift to the community.”































203 Fine Art specializes in regional art, from pre and post-war Taos Moderns to the best contemporary artists. A premier destination gallery offering museum-quality art and a personalized experience. 1335 Gusdorf Rd . Suite i . Taos . NM 203FINEART.com . 575.751.1262 . art@203fineart.com Ceramics and Printmaking
NE ART Early Modern to Contemporary
OPENING OCTOBER 5
New Mexico Potters and Clay Artists (NMPCA) 50th Anniversary “Celebration of Clay”


Jane Burke “Grasses”, graphite on paper, 18” x 24”
4

Our gallery will be closed in September, but please visit us in October for our show of collages by Meghan Wilbar and Anne Farrell (October 12-November 24).
627 Paseo del Pueblo Sur Taos, NM 87571 www.thewrightcontemporary.com 575-224-0530
A Satellite Event to Taos Fall Arts Festival 2024
Saturday, Sep 28 – Saturday, Oct 5, 2024
Reception: Saturday, Sept 28th, 1-6pm
Studios Open Daily: 1-6pm
STUDIO ‘E’XHIBIT 1022 Reed Street, Studio E, Taos, NM
“
BLACK Lines WHITE Spaces”: Taos Artists’ Works on Paper
Nora Anthony, Jane Ellen Burke, Gretchen Ewert, TJ Mabrey, Ginger Mongiello, Janet Webb
MONGIELLO STUDIO 112 Alexander St #B3, Taos, NM
Ginger Mongiello, Painting, Sculpture, Mixed Media
ZARA BELL STUDIO 1036 Reed Street, Taos, NM
Zara Bell, Fiber, Mixed media
JIVAN LEE STUDIO 1022 Reed Street, Studio A, Taos, NM
Jivan Lee, Painting

&

This huge FREE community-wide event is for children of all ages and their families. The ghoulish fun will spill from the Taos Plaza over to Teresina Lane, to Juan Largo Lane, to the John Dunn Shops and Bent Street. Visit TaosNM.gov, Town of Taos Community Events on Facebook, @townoftaoscommunityevents on Instagram or contact Judy Esquibel at 575-751-2037 or at jesquibel@taosnm.gov


The Dixon Studio Tour is the oldest continuously running Tour in the state; the 2024 tour is our 43rd. They’ll have 53 participants including artists, craftspeople, farmers, galleries, wineries, eateries, a healing center and an event venue. This year’s tour is dedicated to Stanley Crawford, award-winning author,































































































































































